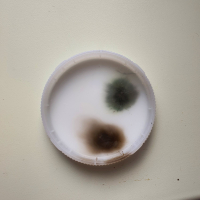
Фото к отзыву на компанию Новый отзыв

Отзыв заказчика на компанию «Home Decor»
Лучше не связываться
Обращался в эту шаражку для монтажа потолков в доме на 2 этаже в Подмосковье (80 кв.м). Замерщик приехал быстро, довольно адекватный, насчитал 70 т.р. за простые потолки из пвх полотна с 9 светильниками и одной закладной под карниз.(Позже из разговора монтажников узнал, что "если бы не 70 рублей, ***(член) бы они поперлись устанавливать мне потолки). Отдельно здесь надо отметить, что на цены, размещенные на сайте, ориентироваться нельзя даже приблизительно, они настолько далеки от реальности, что проще поверить в лепреконов! Отдельно заплатил за леса!!, так как надо было монтировать потолок на лестничном пролете.
Что получил:
- лесов я так и не увидел, обошлись стремянкой (хорошо, что своей);
- вместо сатинового полотна в санузлах (о котором договаривались), натянули матовое;
- все закладные (под люстры, карниз) и светильники монтажники установили, видимо обладая огромным опытом и высочайшим дизайнерским вкусом, по своему усмотрению, не потрудившись спросить - куда они планировались;
- несмотря на то, что обещали пользоваться пылесосом при сверлении, после монтажа остались по периметру помещений горы бетонной пыли.
И, вишенка на торте: через 5 дней после монтажа взорвался (не шучу!) один из светильников (фото прилагаю). И тут у меня начались пляски с гарантией! Написал письменную рекламацию на почту - игнор, по телефону сказали, что обращение рассматривают (привет чиновничьи бюрократы!), потом игнор. Связался с замерщиком, который показался адекватным, узнал что: могут приехать поменять лампу, когда "кто-нибудь будет рядом" (спойлер: никогда) или же я могу сам к ним приехать в Химки и забрать лампу (через всю Москву, ага). На мои опасения, что что-то не так в проводке, ибо светильник не просто перегорел, а взорвался - игнор.
В итоге прошел уже месяц, ничего не поменялось, поэтому, если вдруг кого-то все-таки черт дернет заказывать у этих бракоделов потолки, на гарантию рассчитывать точно не стоит, остануться они со всеми проблемами один на один.
П.С. на фото крышка светильника отдельно, потому, что ее просто выбило.
Что получил:
- лесов я так и не увидел, обошлись стремянкой (хорошо, что своей);
- вместо сатинового полотна в санузлах (о котором договаривались), натянули матовое;
- все закладные (под люстры, карниз) и светильники монтажники установили, видимо обладая огромным опытом и высочайшим дизайнерским вкусом, по своему усмотрению, не потрудившись спросить - куда они планировались;
- несмотря на то, что обещали пользоваться пылесосом при сверлении, после монтажа остались по периметру помещений горы бетонной пыли.
И, вишенка на торте: через 5 дней после монтажа взорвался (не шучу!) один из светильников (фото прилагаю). И тут у меня начались пляски с гарантией! Написал письменную рекламацию на почту - игнор, по телефону сказали, что обращение рассматривают (привет чиновничьи бюрократы!), потом игнор. Связался с замерщиком, который показался адекватным, узнал что: могут приехать поменять лампу, когда "кто-нибудь будет рядом" (спойлер: никогда) или же я могу сам к ним приехать в Химки и забрать лампу (через всю Москву, ага). На мои опасения, что что-то не так в проводке, ибо светильник не просто перегорел, а взорвался - игнор.
В итоге прошел уже месяц, ничего не поменялось, поэтому, если вдруг кого-то все-таки черт дернет заказывать у этих бракоделов потолки, на гарантию рассчитывать точно не стоит, остануться они со всеми проблемами один на один.
П.С. на фото крышка светильника отдельно, потому, что ее просто выбило.
Преимущества:
Хорошие продажники
Недостатки:
бракоделы, отказывают в гарантии
Начать дискуссию
Авторизируйтесь чтобы оставить комментарий.